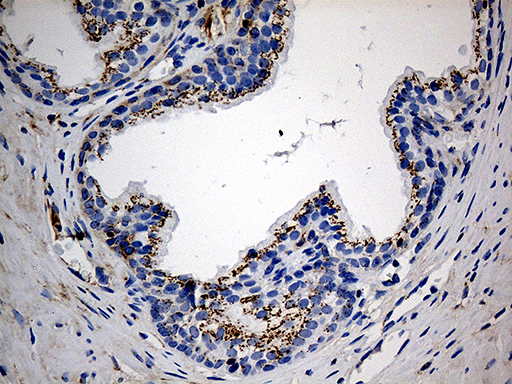
m00581 anti ptpn22 mouse monoclonal antibody clone id oti6b1 ihc testing 4
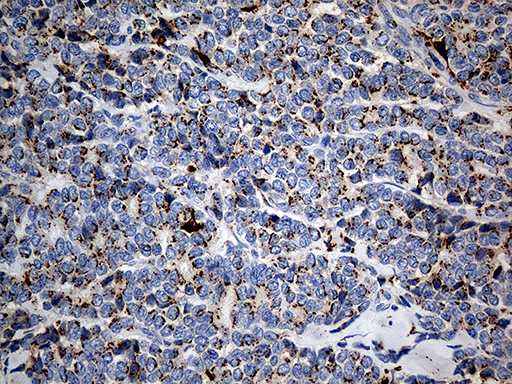
m00581 anti ptpn22 mouse monoclonal antibody clone id oti6b1 ihc testing 7
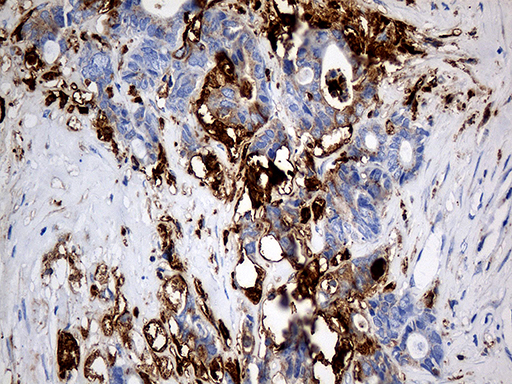
m00581 anti ptpn22 mouse monoclonal antibody clone id oti6b1 ihc testing 10
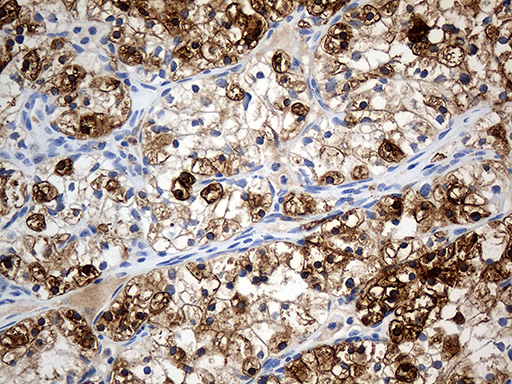
m00581 anti ptpn22 mouse monoclonal antibody clone id oti6b1 ihc testing 12
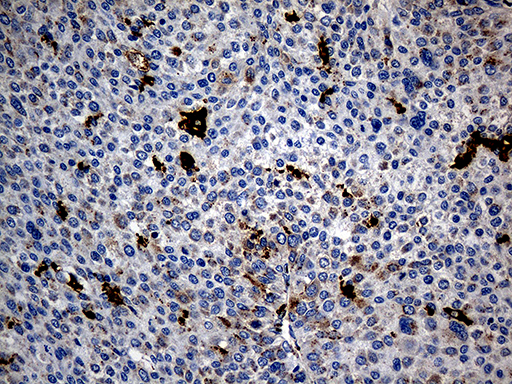
m00581 anti ptpn22 mouse monoclonal antibody clone id oti6b1 ihc testing 13

Product Info Summary
| SKU: | M00581 |
|---|---|
| Size: | 100 µl |
| Reactive Species: | Human |
| Host: | Mouse |
| Application: | IHC, WB |
Customers Who Bought This Also Bought
Product info
Product Name
Anti-PTPN22 Mouse Monoclonal Antibody [Clone ID: OTI6B1]
SKU/Catalog Number
M00581
Size
100 µl
Description
Boster Bio PTPN22 mouse monoclonal antibody,clone OTI6B1. Catalog# M00581. Tested in IHC, WB. This antibody reacts with Human.
Storage & Handling
Store at -20°C as received.
Cite This Product
Anti-PTPN22 Mouse Monoclonal Antibody [Clone ID: OTI6B1] (Boster Biological Technology, Pleasanton CA, USA, Catalog # M00581)
Host
Mouse
Contents
PBS (pH 7.3) containing 1% stabilizing protein, 50% glycerol and 0.02% sodium azide.
This antibody is supplied in a stabilized formulation.
Compatibility with conjugation reactions depends on the chemistry of the conjugation method used.
For conjugation methods that are not compatible with the stabilizing components present in this formulation, a carrier-free antibody format is required.
Clonality
Monoclonal
Clone Number
OTI6B1
Isotype
IgG1
Immunogen
Human recombinant protein fragment corresponding to amino acids 359-449 of human PTPN22 (NP_057051) produced in E.coli.
Reactive Species
M00581 is reactive to PTPN22 in Human
Observed Molecular Weight
91.5 kDa
Calculated molecular weight
91.7 kDa
Antibody Validation
Boster validates all antibodies on WB, IHC, ICC, Immunofluorescence, and ELISA with known positive control and negative samples to ensure specificity and high affinity, including thorough antibody incubations.
Application & Images
Applications
M00581 is guaranteed for IHC, WB Boster Guarantee
Recommend Dilution
WB: 1:2000
IHC: 1:1000
Validation Images & Assay Conditions

Click image to see more details
HEK293T cells were transfected with the pCMV6-ENTRY control (Left lane) or pCMV6-ENTRY PTPN22 (Right lane) cDNA for 48 hrs and lysed. Equivalent amounts of cell lysates (5 ug per lane) were separated by SDS-PAGE and immunoblotted with anti-PTPN2.

Click image to see more details
Immunohistochemical staining of paraffin-embedded Adenocarcinoma of Human endometrium tissue using anti-PTPN22 mouse monoclonal antibody. (Heat-induced epitope retrieval by 1mM EDTA in 10mM Tris buffer (pH8.5) at 120°C for 3min

Click image to see more details
Immunohistochemical staining of paraffin-embedded Human prostate tissue within the normal limits using anti-PTPN22 mouse monoclonal antibody. (Heat-induced epitope retrieval by 1mM EDTA in 10mM Tris buffer (pH8.5) at 120°C for 3min
Click image to see more details
Immunohistochemical staining of paraffin-embedded Carcinoma of Human prostate tissue using anti-PTPN22 mouse monoclonal antibody. (Heat-induced epitope retrieval by 1mM EDTA in 10mM Tris buffer (pH8.5) at 120°C for 3min

Click image to see more details
Immunohistochemical staining of paraffin-embedded Human lymph node tissue within the normal limits using anti-PTPN22 mouse monoclonal antibody. (Heat-induced epitope retrieval by 1mM EDTA in 10mM Tris buffer (pH8.5) at 120°C for 3min

Click image to see more details
Immunohistochemical staining of paraffin-embedded Human lymphoma tissue using anti-PTPN22 mouse monoclonal antibody. (Heat-induced epitope retrieval by 1mM EDTA in 10mM Tris buffer (pH8.5) at 120°C for 3min
Click image to see more details
Immunohistochemical staining of paraffin-embedded Adenocarcinoma of Human breast tissue tissue using anti-PTPN22 mouse monoclonal antibody. (Heat-induced epitope retrieval by 1mM EDTA in 10mM Tris buffer (pH8.5) at 120°C for 3min

Click image to see more details
Immunohistochemical staining of paraffin-embedded Human colon tissue within the normal limits using anti-PTPN22 mouse monoclonal antibody. (Heat-induced epitope retrieval by 1mM EDTA in 10mM Tris buffer (pH8.5) at 120°C for 3min

Click image to see more details
Immunohistochemical staining of paraffin-embedded Human appendix tissue within the normal limits using anti-PTPN22 mouse monoclonal antibody. (Heat-induced epitope retrieval by 1mM EDTA in 10mM Tris buffer (pH8.5) at 120°C for 3min
Click image to see more details
Immunohistochemical staining of paraffin-embedded Adenocarcinoma of Human colon tissue using anti-PTPN22 mouse monoclonal antibody. (Heat-induced epitope retrieval by 1mM EDTA in 10mM Tris buffer (pH8.5) at 120°C for 3min

Click image to see more details
Immunohistochemical staining of paraffin-embedded Human Kidney tissue within the normal limits using anti-PTPN22 mouse monoclonal antibody. (Heat-induced epitope retrieval by 1mM EDTA in 10mM Tris buffer (pH8.5) at 120°C for 3min
Click image to see more details
Immunohistochemical staining of paraffin-embedded Carcinoma of Human kidney tissue using anti-PTPN22 mouse monoclonal antibody. (Heat-induced epitope retrieval by 1mM EDTA in 10mM Tris buffer (pH8.5) at 120°C for 3min
Click image to see more details
Immunohistochemical staining of paraffin-embedded Carcinoma of Human liver tissue using anti-PTPN22 mouse monoclonal antibody. (Heat-induced epitope retrieval by 1mM EDTA in 10mM Tris buffer (pH8.5) at 120°C for 3min
Specific Publications For Anti-PTPN22 Mouse Monoclonal Antibody [Clone ID: OTI6B1] (M00581)
Loading publications
Recommended Resources
Here are featured tools and databases that you might find useful.
- Boster's Pathways Library
- Protein Databases
- Bioscience Research Protocol Resources
- Data Processing & Analysis Software
- Photo Editing Software
- Scientific Literature Resources
- Research Paper Management Tools
- Molecular Biology Software
- Primer Design Tools
- Bioinformatics Tools
- Phylogenetic Tree Analysis
Customer Reviews
Have you used Anti-PTPN22 Mouse Monoclonal Antibody [Clone ID: OTI6B1]?
Share your experimental results or join a short interview to earn up to $1,000 in product credits or other rewards.
0 Reviews For Anti-PTPN22 Mouse Monoclonal Antibody [Clone ID: OTI6B1]
Customer Q&As
Have a question?
Find answers in Q&As, reviews.
Can't find your answer?
Submit your question




